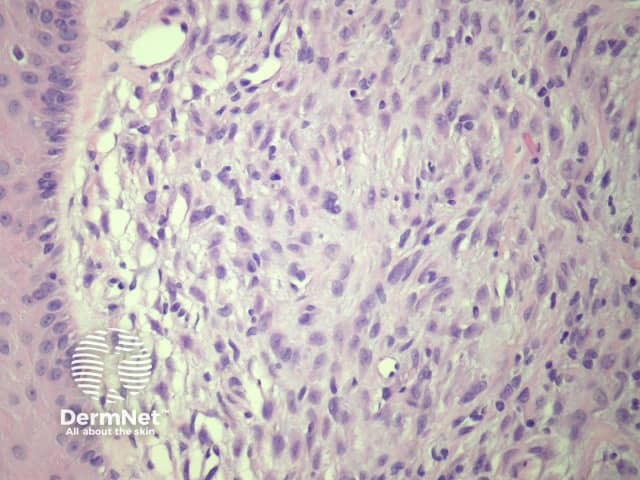
Figure 3
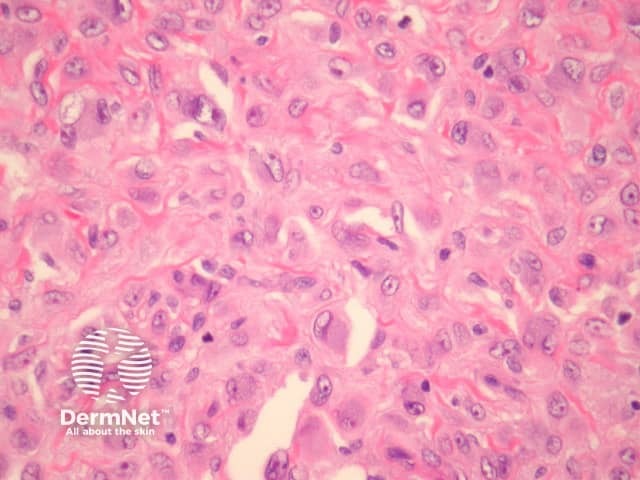
Figure 4

Main menu
Common skin conditions
NEWS
Join DermNet PRO
Read more
Quick links
Lesions (benign) Diagnosis and testing
Author: Assoc Prof Patrick Emanuel, Dermatopathologist, Auckland, New Zealand, 2013.
Epithelioid cell histiocytoma is a well recognised variant of cutaneous fibrous histiocytoma that may be confused with other benign and malignant mesenchymal lesions. It is otherwise known as epithelioid fibrous histiocytoma and epithelioid dermatofibroma.
In epithelioid histiocytoma, sections show a centrally located, circumscribed tumour underlying an epidermal collarette (figure 1). The tumour is composed of epithelioid cells arranged in sheets and sometimes a storiform pattern. Individual cells show abundant eosinophilic cytoplasm with round vesicular nuclei and prominent nucleoli (figures 2-4). The cells may be markedly enlarged and display some nuclear atypia (figure 4).
There is frequently an associated inflammatory cell infiltrate which can be helpful for the diagnosis (figure 3). Some mitoses may be seen. Multinucleated giant cells and haemosiderin deposition are also sometimes seen.

Figure 1

Figure 2
Figure 3
Figure 4
Immunohistochemical studies reveal positivity with Factor 13a, and there is variable positivity with CD68. ALK-1 has been increasingly recognised as being translocated in this tumour. This can be detected with immunohistochemistry or FISH.
Melanoma – Amelanotic melanoma will show similar large epithelioid cells but will generally display more pleomorphism and epidermal involvement. S100 positivity is seen in melanoma.
Epithelioid sarcoma – Granuloma-type clusters with necrosis, more atypia, keratin+.
Other epithelioid dermal tumours – Immunohistochemical studies can help exclude epithelioid vascular, smooth muscle, and histiocytic tumours.